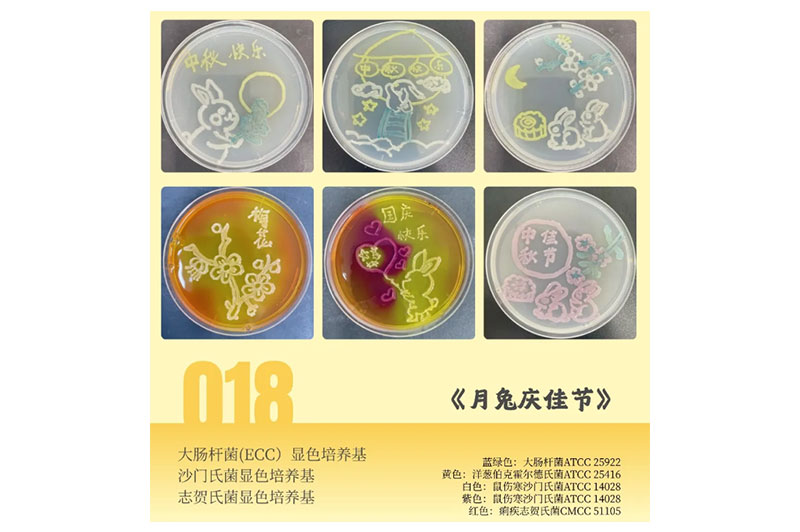
培养基绘画艺术赛获奖作品

公司掠影
工作环境
硬件设施
-

青木固一步成型吹塑机
-

Biopico试剂储存柜
-

ASB 日本一步法注拉吹瓶机
-

纯化水设备
-

化学分析实验室
-

洁净生产车间
-

气相色谱-串联质谱联用仪
-

全自动注塑机
-

全检机器人
-

全自动平皿培养基生产线
-

双通道无菌方瓶灌装系统
-

自动设备
展会一角
-

Aiculture®全国经销商交流大会
-

北京BCEIA展会
-

CLSC科研工具招商会
-

CISILE展会
-

CACLP展会
-

慕尼黑 微生物
-

慕尼黑 微孔过滤
-

慕尼黑 色谱耗材
-

AACC展会
-

CMEF展会
-

MEDICA展会
产学研
员工活动
-

2026第一季度生日会
-

三八女神节(深圳)
-

三八女神节(惠州)
-

入职5周年纪念
-

老员工表彰
-
培养基绘画艺术赛获奖作品
-

季度生日会4
-

季度生日会3
-

季度生日会2
-

中秋品鉴会
-

女神节2
-

女神节1
-

新春慰问
-

第一届职工(代表)大会
-

羽毛球友谊赛
-

季度生日会
-

三八妇女节
-

元宵佳节
-

亲子活动
-

趣享运动会
-

中秋茶话会
-

中秋活动
-

中秋制作灯笼
-

惠州逗点与街道联谊
-

三八红旗手
社区公益




































